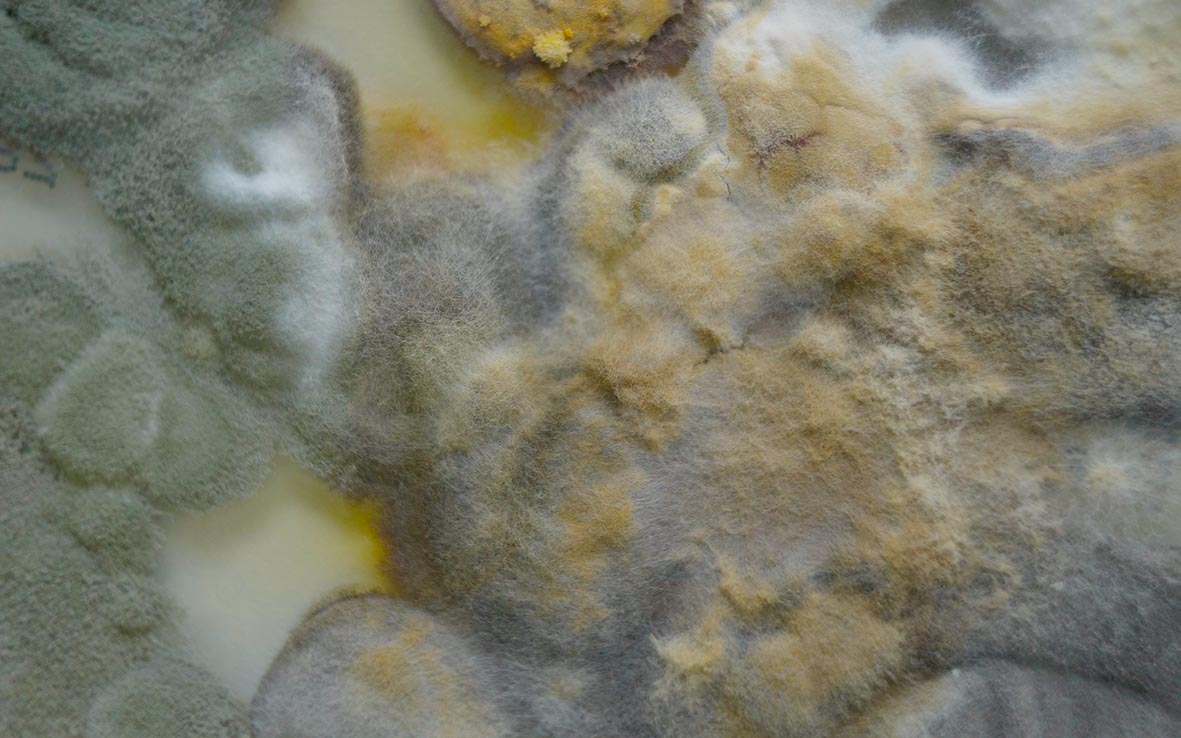

Air Archive
Academy of Fine Arts Vienna2019

Re_Claiming Central
Academy of Fine Arts Vienna2018

Breathing Central
Central Pier n.9 Hong Kong
2017

Tread Softly: The City, Migration, and Memory
Box Freiraum Berlin2017
Tread Softly
Academy of Fine Arts Vienna
2017

The Impossible Order
Berlin Wall Memorial2017

Critical Environment
Academy of Fine Arts Vienna2016

Sudetenland - Tracing Home
Gallery of Architecture Brno2016

The Ambiguity of Peanut
Gallery Mini Brno2015

The Cloth
Contemporary Art Platform Brno2015



Paradise Rekindled
Dusts Collection